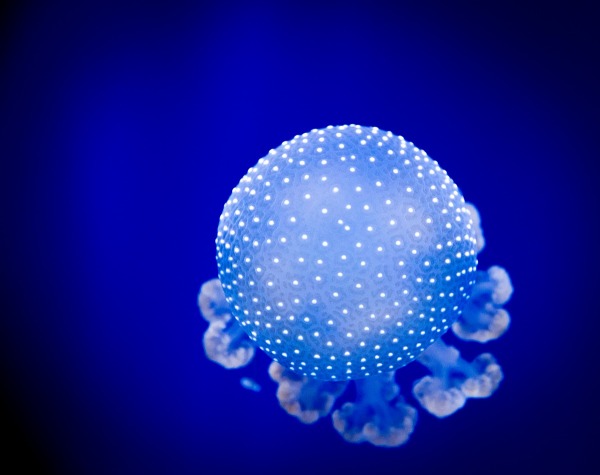
Foto

| Accept Cookies | Customize | Refuse Cookies |
|

All the photos displayed in these galleries are copyright Luca Bradipo and they can not be used without the authorization of the author.
 JuzaPhoto contains affiliate links from Amazon and Ebay and JuzaPhoto earn a commission in case of purchase through affiliate links.
JuzaPhoto contains affiliate links from Amazon and Ebay and JuzaPhoto earn a commission in case of purchase through affiliate links.May Beauty Be Everywhere Around Me